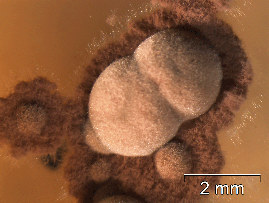

Wallemia sebi
Wallemia sebi ist ein kosmopolitischer, xerophiler Schimmelpilz. In Innenräumen ist er häufig anzutreffen. Er wurde aus Lebensmitteln, der Luft, Böden, Heu, Textilien und aus Menschen und Tieren isoliert. Wallemia sebi kann auch Lebensmittel mit einem hohen osmotischen Druck befallen. Auf getrockneten Lebensmitteln ist dieser Pilz ebenfalls zu finden. Subkutane Infektionen wurden im Zusammenhang mit Wallemia sebi beschrieben. Der Pilz kann Allergien und Infektionen hervorrufen und ist Mykotoxinbildner.